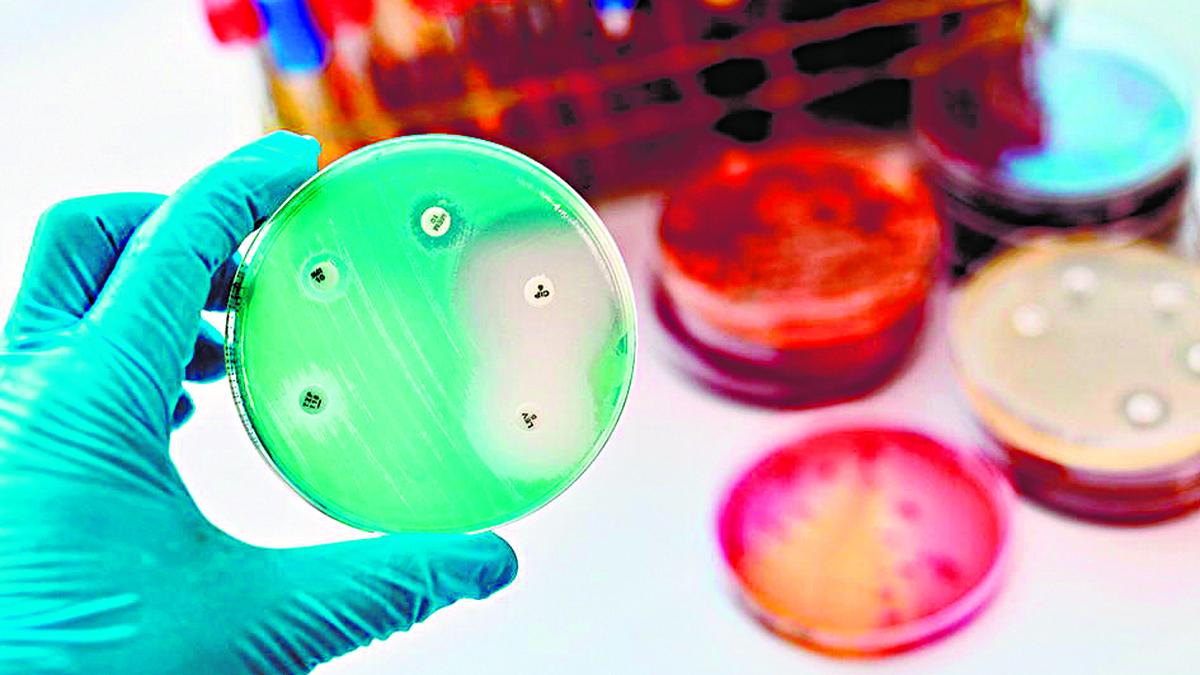

More than 1.1 million Australians are estimated to be living with an eating disorder. Around one-third of these people are neurodivergent.
So why are neurodivergent people, such as autistic people and those with ADHD, more likely to experience eating disorders than the broader population? And how does this impact their treatment?
First, what is neurodivergence?
Neurodivergence, or the state of being neurodivergent, is a term for people whose cognitive functioning differs from what society considers “typical”. Many conditions broadly fall under neurodivergence, including (but not limited to):
- autism
- attention-deficit/hyperactivity disorder (ADHD)
- dyslexia
- Tourette’s syndrome.
Our understanding of neurodivergence has come a long way. Neurodivergence used to be considered a linear “spectrum” ranging from less to more neurodivergent.
We now know every neurodivergent person will have a unique experience across a range of dimensions. This includes sensory processing, motor abilities and executive functioning (working memory, cognitive flexibility and inhibition).
Conceptualising these differences ends up looking more like a colour wheel.
What are eating disorders?
Eating disorders are complex and potentially life-threatening mental health conditions. They cause persistent and significant disturbances in thoughts, feelings and behaviours related to body weight, food and/or eating.
Many factors are likely to contribute to the development of an eating disorder. But research shows neurodivergent people are disproportionately affected.
One review found around 22.9% of autistic people had an eating disorder, compared with 2% in the general population. In another review, people with ADHD were four times more likely to be diagnosed with an eating disorder than people without ADHD.
Why are eating disorders more common among neurodivergent people?
Science has not pinpointed an exact reason why eating disorders are more common among neurodivergent people. But here’s what we know so far.
Neurodivergent people are more likely to experience feeding difficulties, sensory sensitivities and disordered eating.
A United States study assessing the eating behaviour of neurodivergent children found around 70% of autistic children displayed “atypical” eating behaviours. This includes food selectivity and a hypersensitivity to food textures. It compares with 4.8% of neurotypical children.
Similarly, autistic children may choose or reject foods based on texture more than other children. They may prefer foods with a consistent texture, bland taste and neutral colour (for example, chicken nuggets, plain pasta and rice).
Selective eating (having limited accepted foods and food aversions) has been associated with avoidant/restrictive food intake disorder (ARFID). This is an eating disorder characterised by avoidance and aversion to food and eating that is not related to body image. ARFID is commonly associated with autism, with one study estimating 21% of autistic people will experience it in their lifetime.
Other neurodivergent traits, such as perfectionism and a preference for routine, have been associated with disordered eating and eating disorders.
Research on adolescent girls found those with anorexia nervosa are more likely to exhibit neurodivergent (in this case, autistic) traits and behaviours. These include developing rules, resistance to change and a hyperfocus on body weight. These features are commonly seen in anorexia nervosa, an eating disorder characterised by restricted food intake, an intense fear of weight gain and body image disturbances.

Meanwhile, impulsivity symptoms in ADHD have been associated with binge eating disorder. This can involve recurrent episodes of eating large amounts of food in a short period of time. Impulsivity may also be linked to bulimia nervosa, characterised by compensatory behaviours to prevent weight gain after binge eating (such as exessive exercise).
Some studies indicate a link between ADHD, alexithymia (difficulty experiencing, identifying and expressing emotions) and overeating behaviours such as emotional eating.
Finally, neurodivergent people are more likely to identify as part of the LGBTQIA+ community, experience trauma and also have a mental health condition. Each of these considerations increases the likelihood someone will experience an eating disorder.
How does this affect treatment?
Despite the overlap between eating disorders and neurodivergence, current treatment approaches don’t meet the diverse needs of those affected.
Eating disorder treatment often has moderate success at best. For neurodivergent people, the outcomes are worse than for their neurotypical counterparts.
Cognitive behavioural therapy (CBT), a broad range of treatments based on the interaction between thoughts, feelings and behaviours, is less beneficial for neurodivergent people. Yet this is often part of treatment for eating disorders. Autistic women have suggested CBT is less accessible due to its blanket approach and the assumption they have the skills needed to benefit.
There have been calls from organisations such as the National Eating Disorders Collaboration and lived experience advocates to improve access to neurodiversity-affirming care models for neurodivergent people affected by eating disorders.
Such care recognised and safely accommodates the multiple ways neurodivergence is related to feeding and eating behaviour.
Research suggests eating disorder treatment can be successfully adapted for neurodivergent people based on the following principles:
1. equal partnership. Including neurodivergent people as equal partners in their care and as decision-makers, and elevating their own experiences
2. embracing and celebrating differences. Neurodivergent traits should not be considered a deficit, or something to be “treated” or “fixed”. Rather, neurodivergent traits should be celebrated to nourish a positive sense of identity
3. accommodations. Neurodivergent traits and preferences are respected and accommodated. As an example, this might include reducing sensory inputs (the smell, sounds and lights) in a dining area, or a meal plan that is predictable and considers a person’s sensory sensitivities.
Treatment for eating disorders should also be gender-affirming (interventions that support and affirm someone’s gender identity) and trauma-informed.
This article is republished from The Conversation under a Creative Commons license. Read the original article.
Published – October 09, 2024 05:33 pm IST